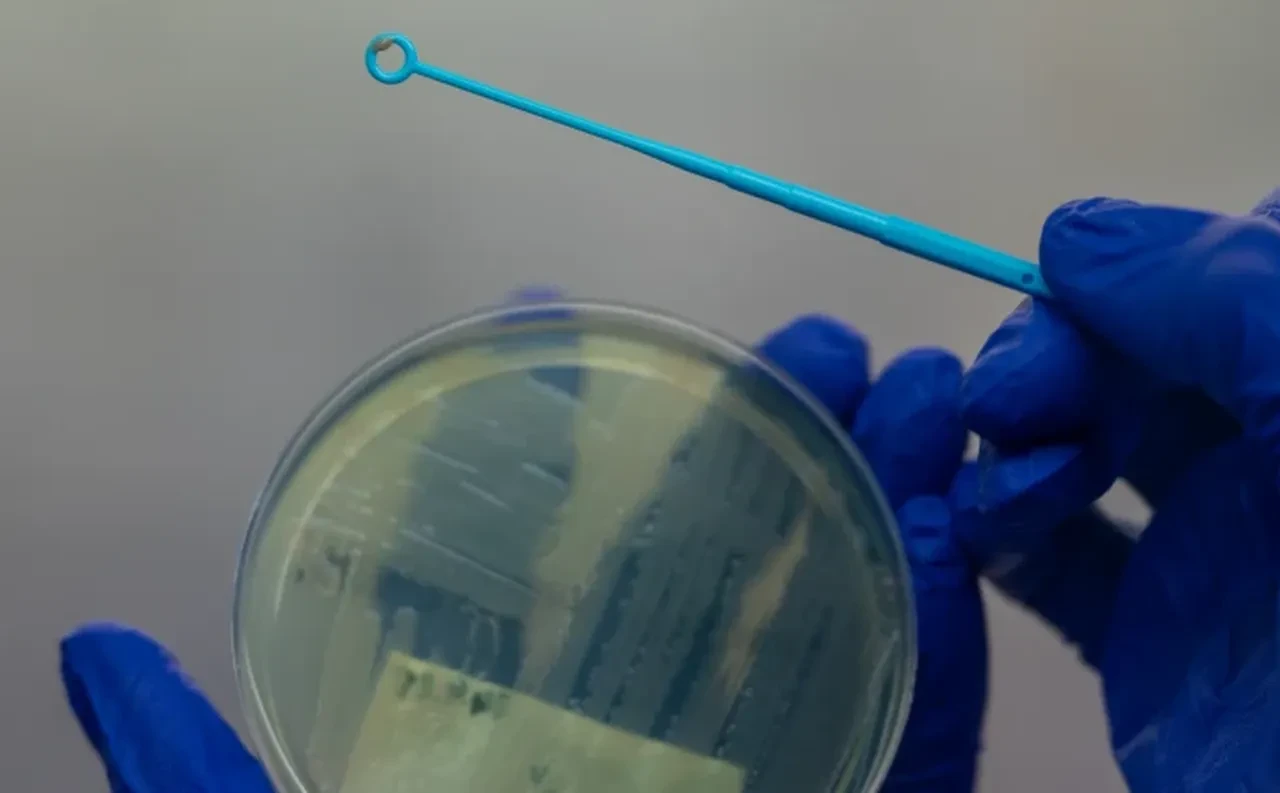
Sağlık sektöründe panik! Hastane cihazlarını yiyen bakteri kabusu!

Kategoriler
UYGULAMALAR
İstanbul

Hastane odalarında, hastaları iyileştirmek için kullanılan tıbbi cihazların aslında ölümcül bir tehdidin hedefi haline geldiği ortaya çıktı. İngiltere'de yapılan çarpıcı bir araştırma, plastikle “beslenen” yeni bir bakteri türünün izine rastladı. Üstelik bu bakteri, sadece plastik malzemeyi yok etmekle kalmıyor, aynı zamanda daha dirençli ve bulaşıcı hale geliyor.
Science Alert'in haberine göre eraştırma, bir hastanın enfekte yarasından alınan örneklerle başladı. Bilim insanları, dünya çapında yılda yarım milyondan fazla ölüme neden olan Pseudomonas aeruginosa adlı bakterinin, şaşırtıcı bir yeteneğe sahip bir alt türünü keşfetti. Bu bakteri, hastanelerde sıklıkla kullanılan biyolojik olarak parçalanabilir plastikleri hedef alıyor. Ve onları yalnızca bozmakla kalmayıp, doğrudan enerji kaynağı olarak kullanıyor.

Bakterinin bu “plastik diyeti”nin arkasında yatan etken, araştırmacıların "Pap1" adını verdiği özel bir enzim. Bu enzim, bakterinin tıbbi cihazlarda bulunan plastik yüzeyleri çözmesine ve içeriğindeki maddeleri adeta bir enerji deposu gibi kullanmasına olanak tanıyor. Laboratuvar ortamında yapılan deneyler, bakterinin bu süreçle daha hızlı büyüdüğünü ve çok daha dirençli hale geldiğini gösterdi.

En çarpıcı bulgulardan biri ise bakterinin oluşturduğu biyofilm adı verilen koruyucu tabaka ile ilgiliydi. Normalde bağışıklık sistemine ve antibiyotiklere karşı koruma sağlayan bu yapı, plastiğin varlığında daha kalın ve dayanıklı hale geliyor. Plastik, adeta bir inşaat malzemesi gibi bu tabakanın içine entegre edilerek, bakteriye ekstra zırh kazandırıyor.
Kateterlerden yapay eklemlere, yanık tedavisinde kullanılan özel pedlerden implantlara kadar birçok tıbbi cihaz, bu bakterinin hedefinde olabilir. Plastik yapıların içine yerleşen bakteriler, tedavileri etkisiz hale getirme ve hastanın durumunu daha da ağırlaştırma potansiyeline sahip.

Bilim dünyası bu yeni tehdide karşı alternatif çözümler üzerinde çalışıyor. Antimikrobiyal katkı maddeleri, plastiği bakterilere karşı “lezzetsiz” hale getirmek için test ediliyor. Ancak uzmanlar, artık sadece işlevsel değil, aynı zamanda bakterilere dirençli malzemelerin geliştirilmesinin hayati önemde olduğunu vurguluyor.
Hastanelerde görünmeyen bu yeni düşman, sağlık sistemlerinin bağışıklık kalkanını delmek üzere. Geleceğin tıbbi cihazları, yalnızca tedavi etmeli değil, aynı zamanda kendilerini de koruyabilmeli.